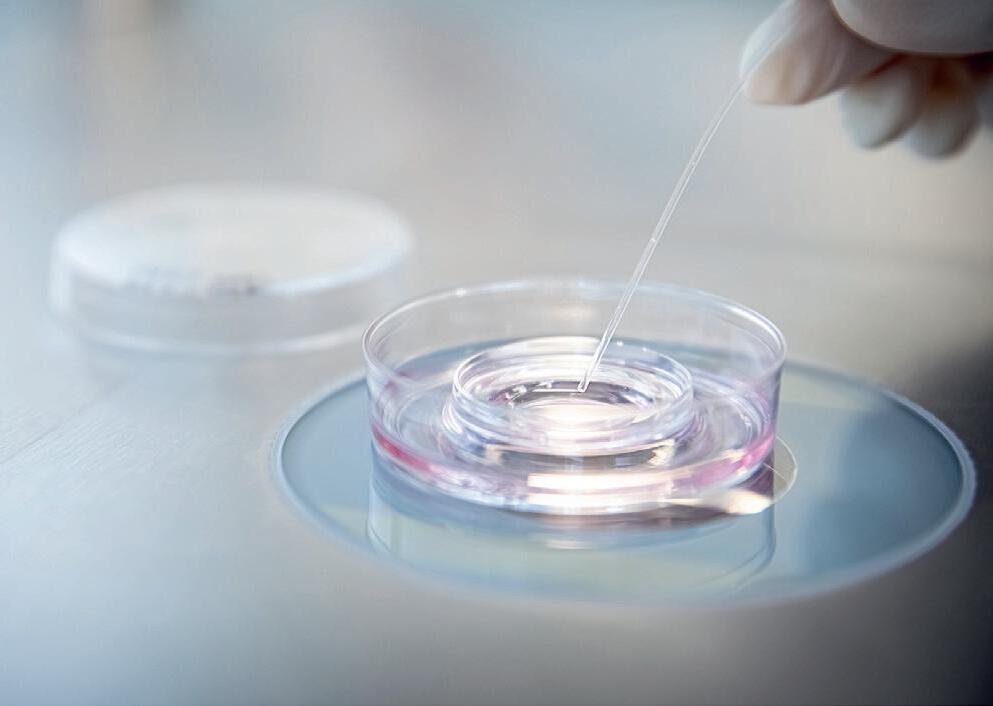

Hela denna tematidning är en annons från Mediaplanet

Läs mer på folkhalsasverige.se

Hela denna tematidning är en annons från Mediaplanet

Läs mer på folkhalsasverige.se

TENA. Så hanterar du inkontinens under graviditeten och efter förlossning.
Nordic IVF. Äggdonation: En ovärderlig gåva och en omsorgsfull process. 11
Ovumia. Äggfrysning kan hjälpa kvinnor att bevara eller förlänga sin fertila period.

Pureness
Att förbättra din sömnkvalitet och hantera stress är nyckelfaktorer för din hälsa. När sömnen lider påverkar det också din förmåga att hantera stress.

Barnmorskorna tipsar!
Det finns mycket du själv kan göra för att öka dina förutsättningar för att bli gravid. Ta del av råden och hjälp naturen på traven.


Så känner du igen järnbrist Ungefär var tredje fertil kvinna i världen är påverkad av järnbrist. Det är viktigt att känna till symptomen, som kan vara di!usa och skilja sig mellan kvinnor.
Projektledare: Filippa Karlenstål (filippa.karlenstal@ mediaplanet.com) Verkställande direktör: Mimmi Holm Redaktionschef: Daniel Petersson A!ärsutvecklare: Celine Lindkvist Distribution: Svenska Dagbladet 03-05-2025 Tryckeri: Bold Printing Mediaplanet kontaktinformation: E-post: daniel.petersson@mediaplanet.com Omslagsfoto: Privat Alla foton ägs av Shutterstock om inget annat anges.
@Mediaplanetsweden
Återvinn gärna tidningen
Paulina Gustafsson
Grundare av FemHealth Summit
FemHealth Summit grundades av Paulina Gustafsson, en passionerad eventskapare och mamma, som genom egna erfarenheter insåg behovet av ökad medvetenhet kring kvinnors hälsa.
När hon och hennes man försökte bli gravida med sitt första barn insåg hon hur lite hon egentligen visste om sin kropp. Hon hade knappt koll på det fertila fönstret och vikten av att förstå menscykeln. Insikten var nästan chockerande – hur kunde denna grundläggande kunskap ha gått henne förbi? Likt många andra hade Paulina gått på preventivmedel sedan tonåren utan att reflektera över sin naturliga cykel. När hon började läsa på insåg hon hur bristen på kunskap påverkar kvinnors hälsa. Men det var först när hon och hennes man försökte få sitt andra barn och mötte oförutsedda svårigheter som hon verkligen insåg hur djupt rotade problemen var. Hennes menscykel var under ett års tid nästan obefintlig. Trots hormonella obalanser och fertilitetsproblem möttes hon av axelryckningar inom vården. Hon fick höra att hon var ung, att hon redan hade ett barn och att hon bara behövde ha tålamod. Men Paulina visste att något var fel.
–När en kvinna söker hjälp för något så sårbart och möts av bristande bemötande, tär det enormt på psyket. Det är lätt att lägga skulden på sig själv och känna sig maktlös.
med sekundär infertilitet fick Paulina till slut diagnosen PCOS, en av de vanligaste orsakerna till infertilitet som drabbar ca 10-15% av fertila kvinnor. PCOS är fortfarande en underforskad diagnos. Historiskt sett har forskning om kvinnors hälsa varit underprioriterad, vilket gör att kvinnor ofta lider i åratal utan rätt hjälp. Hennes upplevelser genom åren har blivit en väckarklocka för hur avgörande det är att kvinnor får tillgång till korrekt diagnos och behandling. Paulina fick tillslut sin diagnos hos CMedical, och med rätt behandling är hon nu gravid med sitt andra barn.
Från frustration till handling –skapandet av en plattform för förändring
Paulina bestämde sig för att använda sina erfarenheter som eventarrangör för att skapa mötesplatser för allmänheten där kvinnohälsa lyfts.
–Vi vill förändra hur vi pratar om och ser på kvinnohälsa. Vårt mål är att sprida kunskap, bryta tabun och engagera till en öppen dialog. Samarbeten är en viktig del av vårt arbete, och bland våra partners finns 1,6 & 2,6 miljonerklubben, Euro Accident och CMedical, som nyligen blev en huvudsponsor.
Text FemHealth Summit

PCOS och den långa vägen till rätt diagnos och behandling Månaderna gick och hennes frustration växte. Hon kämpade för att få gehör för sina symtom, men ingen verkade lyssna. Paulinas upplevelse är långt ifrån unik, otaliga kvinnor delar samma erfarenhet av att inte bli tagna på allvar när de söker vård för kvinnospecifika hälsoutmaningar. Efter över ett års kamp
–Att få med CMedical betyder mycket. Deras läkare hjälpte mig att få rätt diagnos och behandling, vilket gjorde att vi kunde bli gravida igen.
Paulina betonar att det är viktigt att vi inte bara vänder oss till kvinnor, alla behöver inkluderas i samtalen för att vi ska kunna skapa verklig förändring. Vill du vara en del av förändringen? Kom på FemHealth Empowerment Summit den 30 mars på Hotel At Six i Stockholm och delta i samtalen som gör skillnad.
— En komplex men hoppfull resa
är jag fick min endometriosdiagnos var det en lättnad att få en förklaring, men samtidigt väcktes en stark oro. Vid 23 års ålder var familjebildning inget jag hunnit tänka på, men plötsligt förändrades allt. Skulle jag kunna få barn? Den tanken oroade mig länge. Idag har jag och min fästman inga barn än, men jag känner hopp. När jag insåg att 75 % av de drabbade får barn, även om det ibland tar tid och kräver hjälp, kände jag lättnad. Endometrios påverkar många aspekter av kvinnors hälsa, och fertilitet är en av de största orosmomenten. Sjukdomen kan göra det svårare att bli gravid, men korrekt information är avgörande: majoriteten lyckas bli gravida. Vissa
behöver hjälp via assisterad befruktning och IVF, men det betyder inte att hoppet är ute. Vi på Endometriosföreningen vill inge hopp och sprida kunskap. Ingen ska känna sig ensam i sin oro. En tidig diagnos är avgörande för att få rätt vårdstöd. En kvinna utan diagnos behöver vänta minst ett år innan IVF eller annan fertilitetsbehandling kan erbjudas, medan en kvinna med diagnos kan få hjälp inom några månader. Tidig upptäckt är avgörande för individens hälsa och framtid, men också en fråga som kräver att våra beslutsfattare tar sitt ansvar. Sjukvården och skolan måste fånga upp unga tjejer i tid för att undvika onödiga hinder. Ingen ung kvinna ska behöva växa upp i ovisshet och kämpa för sin rätt till familjebildning.


Bli medlem du också för att stötta Endometriosföreningens arbete i Sverige!



Inkontinens är vanligt under graviditet och efter förlossning. Forskning visar att en av tre kvinnor över 35 upplever någon form av inkontinens och att mammor upplever fler symtom än i någon annan fas i livet.
Kroppen genomgår många förändringar under graviditet och förlossning, vilket påverkar bäckenbotten och urinblåsan mycket. Det är vanligt med urinläckage, inkontinens, under graviditeten och efter förlossning.
Det finns flera vanliga orsaker till att toalettbesöken ofta blir mer frekventa när du är gravid och det är inget du behöver oroa dig för. Under graviditeten ökar blodvolymen gradvis, vilket får njurarna att producera mer urin och du behöver gå på toaletten oftare. När livmodern expanderar i takt med att din bebis växer så trycker den på din blåsa. Dessutom försvagar de hormoner som förbereder dina ligament och leder för förlossningen de muskler som kontrollerar urinflödet. Detta påverkar stödet runt urinvägarna, vilket gör att små läckage lättare inträ!ar när trycket mot bäckenbotten och urinröret ökar. Urinläckage inträ!ar vanligtvis under den senare delen av graviditeten och under de första veckorna efter förlossningen, men kan även förekomma under en längre tid.
Förebygg inkontinens med enkla övningar
Om förlossningen inneburit mycket krystande och påfrestningar så har det en oundviklig påverkan på bäckenbotten, vilket kan innebära en viss förlust av blåskontroll en tid därefter. Risken ökar om barnet varit stort vid födseln (över 4 kg) eller vid långdragen, svår förlossning vilket ökar risken för skador på bäckenbottenmuskulaturen och nerverna som kontrollerar urinblåsan. Om du bekymrar dig för att du har allvarligare problem med urinblåsan är det alltid bra att ta upp det med din läkare.
Ett tips för att minska risken för urinläckage är att stärka din bäckenbotten med enkla regelbundna övningar. Bäckenbottenträning (som innebär att man spänner och slappnar av bäckenbotten) är inte bara nyttigt under graviditeten och efter förlossningen. Övningarna kan vara fördelaktiga i livets alla faser och därför rekommenderar experterna att man gör dem dagligen. På tena.nu finns flera instruktionsfilmer som hjälper dig att komma igång.
Låt inte urinläckagen styra ditt liv Att använda vanliga mensskydd kanske är ditt första val när du upplever urinläckage, men dessa är inte anpassade för att hantera snabba urinflöden. TENA inkontinensskydd absorberar urinen mycket snabbare och bevarar en ren och fräsch känsla. Ytskiktet och distributionslagren har utformats speciellt för snabba urinflöden, till skillnad mot mensskydd som är gjorda för tjockare flöden som blod.
Skydden från TENA består av absorberande polymerer som liknar små pärlor. Dessa sväller och omvandlas till gelé vid kontakt med vätska. De kapslar in kisset så att både din hud och skyddet förblir torrt. TENA motverkar dessutom oönskad lukt från urinen och ger en fräsch känsla.
Låt inte urinläckge styra hur du lever ditt liv. Genom att använda produkter från TENA kan du koppla av och veta att du håller dig torr, fri från lukt och bekväm om läckage inträ!ar, oavsett omständigheterna.

Elegant och diskret inkontinensskydd för kvinnor. Nya TENA Silhouette Plus ger precis det skydd du behöver, så du kan klä dig som du önskar och leva livet på dina villkor. TENA.nu


Kvinnohälsa är ett vitt begrepp som berör alltifrån normalfysiologiska förlopp som till exempel menscykeln, graviditet och klimakterium till sjukdomar och behandlingar där könshormoner spelar en stor roll.


Angelica Lindén Hirschberg
Gynekolog & professor, Karolinska Universitetssjukhuset och
Karolinska Institutet
Många hävdar att kvinnohälsa är ett oprioriterat område för forskning och innovation. Kan det delvis bero på att gränsen för det normalfysiologiska och onormala ibland kan vara svårdefinierad? Ska vi verkligen behandla premenstruella besvär och klimakteriesymtom? För vissa kan det vara kontroversiellt. Faktum är dock att många kvinnor lider svårt av sådana symtom med en påtaglig negativ inverkan på både livskvalitet och arbetsförmåga. Basal kunskap saknas inom flera områden av kvinnohälsa. Här nedan ges exempel på tillstånd som behöver uppmärksammas och där mer forskning kan bidra till förbättrad hälsa hos kvinnor.
Cirka 75 procent av alla kvinnor i fertil ålder har någon form av återkommande fysiska eller mentala symtom i samband med menstruationscykeln som oftast är milda men 3-5% har uttalade premenstruella symtom som
nedstämdhet, oro och irritabilitet med påtagliga konsekvenser för det dagliga arbetet, sociala aktiviteter och relationer. Flera sjukdomar kan också förvärras i relation till menscykeln som migrän, astma och autoimmuna sjukdomar.
Oönskad barnlöshet är idag ett växande problem som kan ha många orsaker där bland annat ålder, miljö- och livsstilsrelaterade faktorer kan spela roll för hormonell balans och fertilitet hos båda könen. Ofrivillig barnlöshet kan i många fall avhjälpas med assisterad befruktning men det är inte alla som kan erbjudas sådan behandling och inte heller alla lyckas. Det är väl känt vilken psykologisk belastning det innebär för båda i en parrelation eller som ensamstående att drabbas av ofrivillig barnlöshet.
Klimakteriet är en naturlig biologisk händelse och benämner tiden före och efter den sista menstruationen (menopaus). Under denna period minskar successivt
Basal kunskap saknas inom flera områden av kvinnohälsa.
Angelica Lindén Hirschberg
östrogenproduktionen från äggstockarna, vilket kan leda till olika symtom. Cirka 75% av alla kvinnor drabbas av värmevallningar, svettningar och sömnproblem och en tredjedel av alla kvinnor i klimakterieåldern har så svåra besvär att de önskar någon form av behandling. Det finns många myter och missledande uppfattningar om klimakteriet och hormonbehandling samt bristande kunskap inom vården som gör att kvinnor inte får den hjälp som de borde har rätt till.

Allt fler kvinnor väljer att frysa sina ägg för att ge sig själva möjligheten att bli föräldrar när tiden är rätt. Oavsett om det handlar om att satsa på karriären, resa, eller att ännu inte ha trä!at rätt partner, erbjuder äggfrysning en möjlighet att ta kontroll över sin fertilitet.
De flesta kvinnor vi möter fryser sina ägg av icke-medicinska skäl. Det handlar om att skapa en trygghet inför framtiden, en chans till föräldraskap när det passar bäst, säger Dr. Anna-Lena Wennberg, medicinskt ansvarig för Nordic Egg Bank på Nordic IVF.
Hur går processen till?
Nordic IVF har tre kliniker i Sverige: Nordic IVF i Göteborg och Malmö samt Stockholm IVF i Stockholm.
Äggfrysning är en beprövad metod som liknar den vid en IVF-behandling.
Först genomgår kvinnan en hormonell stimulering för att få äggstockarna att mogna fler ägg än vid en naturlig cykel.
– Under cirka tio dagar tar kvinnan hormonsprutor hemma och kommer
in på regelbundna ultraljudskontroller. När äggen är mogna plockas de ut genom ett enkelt vaginalt ingrepp med lokalbedövning, förklarar Dr. Wennberg. Därefter fryses äggen ner med en snabbfrysningsmetod som kallas vitrifiering. På så sätt kan de bevaras i många år utan att förlora sin kvalitet.
När är det bäst att frysa sina ägg? Enligt Dr. Wennberg är den optimala åldern för äggfrysning mellan 30 och 35 år.
– Vid den åldern har kvinnan fortfarande bra kvalitet på sina ägg och en hög äggreserv, vilket ökar chanserna att frysa ett tillräckligt antal ägg av god
Att donera sina ägg är en generös handling som kan förändra livet för någon som längtar efter barn. Men det är också en process som kräver både eftertanke och noggrannhet. Därför genomgår varje donator en omfattande medicinsk och personlig utredning för att säkerställa att både de själva och mottagaren får den bästa möjliga förutsättningen.
För att säkerställa en trygg och säker process vid äggdonation krävs det att donatorn är mellan 23 och 36 år, rökfri och vid god hälsa. Dessutom granskas familjehistoriken noggrant för att utesluta ärftliga sjukdomar.
– Det är en omsorgsfull process, men den finns där för att skapa trygghet, både för donatorn och för den som tar emot ägget, förklarar Dr. Anna-Lena Wennberg, medicinskt ansvarig för Nordic Egg Bank på Nordic IVF.
Hur går det till?
kvalitet, säger hon. Även om ingen metod kan garantera en framtida graviditet, ser många kvinnor äggfrysning som en investering i sin frihet och trygghet.
– Det handlar om att ge sig själv möjligheten att få barn senare i livet. För vissa blir det ett alternativ, för andra en trygghet i vetskapen om att de har en backup-plan, säger Dr. Wennberg. Med ökad kunskap och tekniska framsteg blir äggfrysning ett alltmer tillgängligt val – ett sätt för kvinnor att själva styra över sin fertilitet och framtid.

Anna-Lena Wennberg Medicinskt ansvarig

Om alla tester ser bra ut och donatorn godkänns, inleds den hormonella behandlingen. Under cirka tio dagar tas hormonsprutor för att stimulera äggstockarna att mogna flera ägg än vid en naturlig cykel. Behandlingen övervakas med regelbundna ultraljud och blodprover för att säkerställa att kroppen svarar som den ska.
–När äggen är mogna genomförs ägguttaget. Det är ett kort ingrepp med hjälp av ultraljud där vi försiktigt plockar ut äggen via en tunn nål genom slidväggen. Ingreppet sker oftast under lokalbedövning, förklarar Dr Wennberg.
Reglerad och säker äggdonation i Sverige
I Sverige är alla äggdonationer öppna, vilket innebär att barnet har rätt att få veta vem donatorn är när hen blir vuxen. Det finns också tydliga regler för att skydda både donator och mottagare genom hela processen.
– En fördel med att genomföra äggdonation i Sverige är att det sker
Det är en omsorgsfull process, men den finns där för att skapa trygghet, både för donatorn och den som tar emot ägget.
under trygga, reglerade former. De kvinnor som väljer att donera sina ägg gör det enbart av viljan att hjälpa någon annan att få uppleva glädjen i att bli förälder. De är helt fantastiska! Säger Dr Anna-Lena Wennberg.
Genom att öka medvetenheten kan fler kvinnor få chansen att hjälpa andra, och samtidigt ge hopp om ett efterlängtat familjeliv. En gåva som kan förändra liv för alltid.
Att förbättra din sömnkvalitet och hantera stress är
nyckelfaktorer för din hälsa. När sömnen lider påverkar det också din förmåga att hantera stress, och vice versa. Låt oss utforska hur du kan optimera dessa områden för att främja både fysisk och mental hälsa.

Stressreaktionen och dess påverkan
Kroppen är konstruerad för att reagera på stress genom att mobilisera energi för att hantera hotande situationer.
Denna ”fight-or-flight” respons involverar frisättning av hormoner som adrenalin och kortisol. Adrenalin höjer hjärtfrekvensen och blodtrycket, medan kortisol ökar blodsockernivåerna och riktar energi till hjärnan.
Kortisolens roll och dess påverkan på kroppen
Kortisol följer en naturlig daglig rytm med höga nivåer på morgonen och lägre på kvällen. Kronisk stress kan dock leda till konstant förhöjda nivåer av kortisol, vilket inte är optimalt för hälsan. För att hantera detta är det viktigt att reglera stress genom att identifiera och hantera dess olika former: fysisk, psykologisk, psykosocial och psykospirituell.
Sömnens betydelse för stress och hälsa
Sömn är nära kopplat till kortisolnivåerna. En god natts sömn är



avgörande för att kroppen ska kunna återhämta sig och hantera stress e!ektivt. Sömnbrist kan leda till en rad negativa konsekvenser såsom ökad aptit, blodsockersvängningar och försämrad mental hälsa.
Praktiska verktyg för att förbättra sömnkvaliteten
För att förbättra din sömnkvalitet finns flera e!ektiva strategier. Att reglera ljusexponeringen under dagen och kvällen är en viktig metod. Dagsljus på morgonen signalerar vakenhet, medan mörkare miljöer på kvällen förbereder kroppen för sömn. Att undvika skärmtid innan läggdags är också avgörande för att inte störa sömncykeln.
Magnesium som ett stöd för sömn och avslappning
Magnesium, särskilt i formen magnesiumbisglycinat, kan bidra till att slappna av musklerna och förbättra sömnen. Detta mineral stöder också produktionen av GABA, en neurotransmittor som främjar avslappning. Att ha tillräckliga nivåer av magnesium är avgörande för
dess e!ektivitet.
Adaptogener för att hantera stress och balansera kortisol
Adaptogener som ashwagandha kan hjälpa till att reglera kortisolnivåerna och stödja kroppens anpassning till stress.
Dessa växter och svampar kan bidra till att öka motståndskraften mot stress och minska risken för utmattning efter en stressperiod.
Hormonhälsa och dess koppling till sömn och stress
Förhöjd stress och dålig sömnkvalitet kan påverka hormonhälsan negativt, särskilt produktionen av könshormoner som är känsliga för stressnivåer. Det är viktigt att hantera stress och optimera sömnen för att upprätthålla en regelbunden hormonbalans.
Genom att implementera dessa verktyg och strategier kan du förbättra din förmåga att hantera stress, optimera din sömnkvalitet och främja en holistisk hälsa på både kort och lång sikt. Att ta hand om dig själv genom att investera i din sömn och stresshantering är en investering i ditt välbefinnande.

Det finns mycket du själv kan göra för att öka dina förutsättningar för att bli gravid. Genom att följa din menscykel, minska stressen i ditt liv, vara medveten om ålderns betydelse för fertiliteten och att ta hand om dig själv och din kropp så kan du lyckas hjälpa naturen på traven.

Den första faktorn man bör vara medveten om när man försöker bli gravid är åldern. Chansen till en graviditet minskar rejält efter 35 års ålder och avtar än mer efter 40 års ålder. Om du vet med dig att du vill ha barn i framtiden så kan det vara bra att göra en ungefärlig plan för vid vilken ålder du vill ska!a barn, säger Lotta Hasselberg, barnmorska på ungdomsmottagning online i Region Stockholm.
Följ din menscykel via en app eller menskalender. Det hjälper dig att ta reda på när du har ägglossning och därmed även vilka dagar i månaden du är som mest fertil.
–Stress har en negativ påverkan på kroppen på många sätt och kan därmed även indirekt påverka dina chanser att bli gravid. Kraftig stress kan exempelvis leda till utebliven ägglossning. Försök därför att minimera stressen i ditt liv, inte minst eventuell stress inför att bli gravid. Sträva

efter balans, glöm inte att njuta av livet även om du försöker bli gravid. Lev sunt men gå inte till några överdrifter vad gäller exempelvis kost och motion, säger Sofia Strand, barnmorska och enhetschef Stockholms ungdomsmottagning online i Region Stockholm.
Folsyra kan påverka graviditeten Om du har en kronisk sjukdom och står på en läkemedelsbehandling för den så bör du berätta för din läkare att du försöker bli gravid. Vissa läkemedel kan nämligen påverka graviditeten. En hög konsumtion av receptfria smärtstillande tabletter kan minska dina graviditetschanser. Om du röker är det en god idé att sluta med det eftersom rökning kan minska din möjlighet att bli gravid. Se också till att du inte har obehandlad klamydia, det riskerar nämligen att skada äggledarna. –Om du planerar att bli gravid inom de närmaste månaderna så rekommenderar jag även ett dagligt kosttillskott med 400
mikrogram folsyra. Folsyra behövs för att fostret ska utvecklas normalt, säger Lotta Hasselberg.
Kontakta sjukvården efter ett år 80 till 85 procent av de par som aktivt försöker bli gravida lyckas inom ett år, men det kan finnas orsaker hos dig eller din partner som gör att du som kvinna har svårt att bli gravid. Kom ihåg att svårigheter med att bli gravid inte nödvändigtvis behöver bero på något fel hos kvinnan, det är lika vanligt att orsaken går att finna hos mannen. –Om du och din partner har försökt bli gravida i ett år utan att lyckas kan det vara dags att söka er till en gynekolog som kan utreda orsakerna till att ni har svårt att bli gravida. Den som är över 35 bör vänta max sex månader med att söka hjälp eftersom fertiliteten minskar efter 35. Om det inte finns någon gynekolog på din hemort kan du i stället kontakta en vårdcentral som kan skicka en remiss till en fertilitetsklinik, säger Sofia Strand.


Att längta efter barn och möta hinder på vägen är en känslomässig berg och dalbana.
För tv-profilen och influencern Lisa Borg och hennes man Henrik har resan varit fylld av utmaningar, men också av styrka och hopp. Genom att dela sin historia vill Lisa bryta tystnaden kring ofrivillig barnlöshet och visa att ingen är ensam i kampen för att bli förälder.
Att höra sitt barns hjärtslag för första gången är en magisk stund för många blivande föräldrar. Men för vissa är vägen dit allt annat än enkel. – Jag växte upp med föräldrar som kämpade för att få barn efter att de fick mig. Det tog tio år av IVF-försök och missfall innan de fick mitt syskon. Jag såg deras kamp på nära håll, både deras styrka och tårar. För mig blev det en självklarhet att vägen till att få barn inte alltid är rak, berättar Lisa. När Lisa trä!ade sin man Henrik var hon redan medveten om att det kunde bli svårt för henne att bli gravid. Hennes mamma hade endometrios, och Lisa hade en stark känsla av att även hon kunde vara drabbad.
– Tidigt i vår relation berättade jag för Henrik att det kunde bli en utmaning för oss att få barn. Jag hade aldrig gjort några tester, men min magkänsla sa att vägen dit skulle bli svår. När vi efter ett halvår fortfarande inte blivit gravida valde vi att göra en privat fertilitetsutredning för att få snabba svar, i stället för att vänta i en lång vårdkö. Har man möjlighet rekommenderar jag verkligen det, säger Lisa.
Trots att alla prover såg bra ut blev det ingen graviditet. Till slut fick Lisa och


Vi har aldrig lagt fokus på att det skulle vara något ”fel” på mig, honom eller oss, utan vi har sett det som en uppgift att lösa tillsammans.
Henrik diagnosen ofrivillig barnlöshet och remitterades till landstinget för IVF. (I Sverige får man tre IVF omgångar gratis).
Missfall och motgångar – men aldrig uppgivenhet Första IVF-försöket ledde till en befruktning, men embryot fäste aldrig. Vid det andra försöket blev Lisa gravid, men fick missfall i sjätte veckan. Sedan kom nästa bakslag, vid ett nytt äggplock gick det inte att få ut ett enda ägg. – Det var nästan tu!are än missfallet. Du genomgår hormonbehandlingar, tar sprutor och går igenom äggplock som är allt annat än behagligt. Och sedan kommer samtalet: ”Tyvärr blev det inga ägg.” Det var en chock. Men som tur är räknas det inte som en av de tre kostnadsfria försöken man får i Sverige. Det tycker jag är så fint! Säger Lisa. Men mitt i sorgen fanns ett ljus –hennes kropp kunde bli gravid.
Stöd och gemenskap i sociala medier
Under hela resan har Lisa och Henrik valt att vara öppna med sina erfarenheter i sociala medier, både på Youtube, Instagram, Tik-Tok och Snapchat. Responsen har varit överväldigande och skapat en känsla av
gemenskap.
– Att dela vår resa har hjälpt oss att orka. Vi har fått meddelanden från följare som berättar om sina missfall och svårigheter att få barn. Det har fått oss att inse att vi inte är ensamma. Det är klart att det varit tu!t att filma vissa stunder, vi har gråtit framför kameran mer än en gång, men stödet vi fått har varit otroligt, säger Lisa.
För Lisa har Henrik varit ovärderlig. –Jag hade aldrig klarat det själv, och jag har enorm respekt för dem som går igenom detta på egen hand. För oss har det alltid varit en gemensam kamp. Det är så viktigt att hålla ihop. Vi har aldrig lagt fokus på att det skulle vara något ”fel” på mig, honom eller oss, utan vi har sett det som en uppgift att lösa tillsammans. Det har gjort oss starkare som par, menar Lisa.
Ett steg närmare drömmen
Idag är Lisa gravid i vecka 14, och allt ser bra ut. I augusti väntas deras lilla mirakel komma till världen.
– Fertilitetsresan är tu!, men vi försöker fokusera på varje steg framåt. En dag kommer vi få uppleva den magiska stunden när vi hör vårt barns första skrik. Den dagen kommer vara värd allt, avslutar Lisa.

Kvinnors hälsa berör alla. Det är en grundpelare för ett fungerande samhälle, men forskning och vård inom området är fortfarande eftersatt. CMedical arbetar för att sätta kvinnohälsa i framkant.


Med kliniker i Stockholm, Uppsala och Norge erbjuds ett nordiskt helhetskoncept där expertis är samlad inom hela spektrumet av kvinnohälsa – från fertilitet och gynekologiska besvär till klimakterievård och avancerad kirurgi.
– CMedical är mer än en klinik, vi är ett kunskapsnav inom kvinnohälsa. Vårt specialistteam arbetar över landsgränserna och kompletterar varandras expertis, vilket gör att vi kan erbjuda bästa möjliga vård till våra patienter. Genom samarbete även med andra vårdgivare säkerställer vi ett holistiskt synsätt där kvinnans hela hälsa står i centrum, säger Kristina Törn, gynekolog och VD på CMedical Sverige.
En ny standard för kvinnohälsovård Kvinnor utgör drygt hälften av jordens befolkning men lever i genomsnitt 25 % mer av sin livstid i ohälsa jämfört med män. En stor del av denna ohälsa drabbar kvinnor i arbetsför ålder. Många av de vanligaste kvinnosjukdomarna, såsom PCOS, endometrios och klimakterierelaterade besvär, har länge varit undervärderade inom vården. Samtidigt påverkas många kvinnor av bäckenbottenskador efter förlossning, vilket kan orsaka urinläckage,
tarmbesvär och framfall. Ofrivillig barnlöshet drabbar dessutom cirka 17,5 % av den vuxna befolkningen, och fertilitetsutredning och behandling är en stor del av kvinnosjukvården. – Att följa hela patientresan är viktigt för både vårdtagare och läkare. Genom att erbjuda en bred expertis inom gynekologi, fertilitet och kirurgi kan vi säkerställa en helhetssyn och gemensamt verka för att erbjuda bästa möjliga vård, förklarar Kristina Törn.
Framtidens fertilitetsvård – trygg och innovativ Provrörsbefruktning (IVF/ICSI) har revolutionerat möjligheten för många att få barn. På CMedicals fertilitetskliniker erbjuds högspecialiserad fertilitetsvård med individanpassade behandlingar och unika laboratorietekniker, för att möta de eventuella utmaningar som självstående, samkönade och heterosexuella par står inför. Där finns god tillgång till donerade könsceller och embryoåterföring genomförs alla dagar i veckan. På kliniken i Stockholm kan även narkos erbjudas vid äggplock för att minska obehag.
– Det känns värdefullt att kunna göra fertilitetsutredning, erbjuda skonsam kirurgi när det är motiverat och därefter göra fertilitetsbehandling på ett och samma ställe. Inte sällan trä!ar vi
Vi strävar efter att göra vården mer tillgänglig genom digitala lösningar där patienter kan boka en konsultation oavsett om det gäller kvinnlig eller manlig infertilitet.
patienter som kämpat med infertilitet under lång tid där vi haft möjlighet att drastiskt förbättra deras chanser, berättar Marcus Bergman, fertilitetsläkare och gynekolog på CMedical. CMedical lanserade under hösten 2024 sitt digitala fertilitetskoncept Fertilitetsdoktorn.se där patienter runt om i Sverige har möjligheten att trä!a erfarna fertilitetsläkare helt online. – Vi strävar efter att göra vården mer tillgänglig genom digitala lösningar där patienter kan boka en konsultation oavsett om det gäller kvinnlig eller manlig infertilitet. Digital vård ger en flexibilitet och tillgänglighet som annars kan saknas inom traditionell sjukvård, säger Marcus Bergman.




Allt fler kvinnor väljer att frysa ner sina ägg för att kunna bli med barn senare i livet. Äggfrysning ger kvinnor en möjligt att ta kontroll över sin fertilitet och förlänga möjligheten till framtida moderskap.
Äggfrysning blir alltmer populärt och ger kvinnor möjlighet att förbereda sig inför framtida graviditet genom att frysa sina ägg. Nathalie Roos är specialist i gynekologi på fertilitetskliniken Ovumia i Stockholm. – Det blir allt vanligare att kvinnor vill frysa sina ägg. Hur stor chansen är att bli gravid och få barn med frysta ägg beror till stor del på hur gammal man är och den så kallade äggreserven. Därför börjar vi alltid med en konsultation där vi gör en individuell bedömning. Det är viktigt att man som fertilitetsklinik förmedlar realistiska förväntningar. Andra faktorer som påverkar är medicinska förutsättningar och kvaliteten på äggen. Det är åldern vid ägguthämtning och nedfrysning som är viktig, inte åldern då de väl används. För en bra chans att äggen ska kunna ge en eventuell graviditet längre fram bör kvinnan vara yngre än 35 år men man gör alltid en individuell bedömning.
Äggfrysning – så går det till I Sverige finns ännu ingen lagstiftning som reglerar äggfrysning. Men man måste kunna bära en graviditet utan uppenbara risker och kvinnan ska inte vara äldre än 45 år när äggen användas
till en graviditet.
– Behandlingen består av en stimuleringscykel där kvinnan tar en spruta dagligen under 10–12 dagar. I slutet av perioden gör man ultraljud och ser om äggblåsorna växer. Om behandlingen har lyckats hämtas äggen ut med hjälp av vaginalt ultraljud i lokalbedövning kombinerat med smärtstillande.
Äggen tas ut i ett rum i direkt anslutning till laboratoriet. Embryologer identifierar vilka ägg som är mogna och som då som går att frysa in. Äggen lagras i flytande kväve med en temperatur på minus 196 grader. Man rekommenderar att man har åtminstone 20–30 ägg i frysen, så ofta behövs det flera behandlingar.
– Vi är ett team som jobbar tätt tillsammans före, under och efter en behandling. Det är tack vare teamet och tekniken i vårt nya labb som vi har möjlighet att göra det här.
Öka sina valmöjligheter
Allmän äggfrysning erbjuds i Sverige bara på privata fertilitetskliniker. Endast kvinnor med sjukdomar som kan leda till infertilitet, till exempel efter cancerbehandling erbjuds äggfrysning av den o!entliga vården.
– Majoriteten av kvinnorna som
Äggfrysning är en fantastisk möjlighet att öka sina valmöjligheter till att längre fram kunna bli mamma och känna mindre stress.
Nathalie Roos
kommer till oss är ensamstående. De flesta har ett långvarigt förhållande bakom sig och ser äggfrysning som en tidsfrist och extra möjlighet för framtiden.
Det är ofta smidigare att genomgå en behandling än vad många föreställer sig. En vanlig missuppfattning är att inte kunna arbeta och träna som vanligt. – De flesta mår precis som vanligt under behandlingen. Det är bara dagen för äggplocket som man ska ta det lugnt och vila, i övrigt kan man både jobba och träna. Äggfrysning är en fantastisk möjlighet att öka sina valmöjligheter till att längre fram kunna bli mamma och känna mindre stress, avslutar Nathalie Roos.


Många kvinnor känner igen sig i de månatliga svängningarna av humör, energi och välmående. Men trots att symtomen är så vanliga är det få som vet hur de faktiskt kan påverka sin cykel på ett positivt sätt och få en bättre livskvalité. Nathalie Ste!ner, Activation Coach, expert på kvinnlig hormonhälsa och grundare av LUNA-metoden, har själv gått igenom en resa från svår PMS till hormonell balans. Idag hjälper hon andra kvinnor att förstå sina cykler och må bättre genom kunskap och livsstilsförändringar.

Du vaknar upp och känner dig irriterad utan anledning. Trött, svullen och med ett sug efter sötsaker som är omöjligt att ignorera. Minsta lilla kommentar får humöret att svänga, och huvudvärken ligger som en dov dimma i bakgrunden. Känns det bekant? För många kvinnor är PMS en återkommande kamp, men tänk om det fanns ett sätt att minska besvären, eller till och med slippa dem helt?

LUNA-Metoden
Vill du veta mer?
Besök hemsidan elexirpharma.se
– Jag brukar kalla PMS för ”prioritera mig själv”, eftersom det i grunden handlar om att kroppen signalerar ett ökat behov av balans och återhämtning. Under cykelns slutskede blir vi mer stresskänsliga, och om vi samtidigt lever i högt tempo eller har näringsbrister kan symtomen förvärras. Förr kände jag mig som ett PMS-monster, men idag märker jag knappt av det, tack vare att jag lärt mig lyssna på min kropp, förstå mina faser och jag började även ta WO-HO, ett hormonbalanserande kosttillskott som förändrade allt, säger Nathalie Ste!ner.
För att må bra behöver vi lyssna på kroppen och anpassa vår livsstil efter menscykelns olika faser: follikelfasen, ägglossningen (då LH och östrogen ökar), lutealfasen (då progesteron produceras) och menstruationsfasen. Det är just denna kunskap Nathalie Ste!ner förmedlar genom LUNA-metoden. –LUNA-Metoden hjälper kvinnor att uppnå ökad balans och välbefinnande. Vi pratar om hormonerna som tre systrar och cykelns faser som fyra årstider, det gör det lättare att förstå och anpassa sin livsstil. Redan som unga får vi höra att det är jobbigt att vara kvinna, men tänk om vi i stället fick veta att vi har fyra faser, var och en med sina egna superkrafter? säger hon.
WO-HO
Miriam Höglund, nutritionist och produktspecialist på Elixir Pharma, förklarar hur tillskottet WO-HO kan bidra till att stabilisera hormonbalansen. –WO-HO är framtagen med avsikt att stödja kvinnors hormonella balans.
Kapslarna innehåller ekologisk kallpressad olja från gurkört, även kallad borago, som är rik på den viktiga fettsyran GLA med många fina egenskaper. Utöver det innehåller den jamsrot, salviaextrakt, vitamin B6 och biotin som hjälper kvinnor att må bättre under hela sin cykel*. För de som inte vill ta gelatinkapslar finns även en flytande version av tillskottet med citronsmak.
Från bättre humör till minskade kramper E!ekterna varierar från person till person, men många upplever en förbättring i humör och energinivåer ganska snabbt. –Vi får otroligt mycket feedback från kvinnor som säger att produkten har hjälpt dem att hantera sin PMS bättre, framför allt vad gäller humörsvängningar och energinivå, berättar Miriam Höglund. Att leva med PMS och hormonell obalans kan vara utmanande, men det finns alternativ som kan hjälpa. Genom att förstå kroppens cykler och behov samt ge den rätt näring, kan många kvinnor få en bättre livskvalitet, varje dag i månaden.

Använd koden WOHO20 och få 20% rabatt på WO-HO på elexirpharma.se
Kosttillskott ersätter inte en varierad kost utan bör kombineras med en mångsidig och balanserad kost och hälsosam livsstil.
*Salvia ger stöd för välbefinnande under menstruationsperioden. Vitamin B6 bidrar till att reglera den hormonella aktiviteten.

Ungefär var tredje fertil kvinna i världen är påverkad av järnbrist.
Symptomen kan vara di!usa och skilja sig mellan kvinnor och behandlingen måste ofta individualiseras för att bli e!ektiv.

Helena Kopp Kallner
Överläkare & docent
på Karolinska Instritutet
Järnbrist kan ta sig uttryck på många olika sätt. Det har ofta att göra med hur snabbt järnbristen uppträder, det vill säga beroende på om den är akut eller kronisk.
– Akut järnbrist kan uppstå efter en förlossning och då kan du få symptom fast du egentligen inte har tappat mycket blod. Har du en kronisk järnbrist, kan kroppen kompensera ganska långt innan du får symptom. Vid kronisk järnbrist kan du dessutom bli deprimerad och nedstämd utöver de andra symptomen, säger överläkare och docent på Karolinska Institutet Helena Kopp Kallner.
Kroppen kompenserar När kroppen kompenserar för järnbrist spär den ut blodet och får hjärtat att slå snabbare. Det gör också att man vänjer sig vid ett lågt blodvärde och anpassar sig.
– Man går allt långsammare för att förhindra obehag. När du kommer till en doktor handlar besöket ofta om att först åtgärda järnbristen och sedan ta reda på varför du har järnbrist. Jag jobbar till exempel med kvinnor som tappar blod för att de menstruerar för mycket. Då behandlar vi först järnbristen och sedan åtgärdar vi orsaken bakom varför man
Järn(III)hydroxidpolymaltoskomplex
Hela familjens järnläkemedel. Finns receptfritt på apotek.

blöder så mycket, säger Helena Kopp Kallner.
Inte slarva med kosten Kvinnor löper större risk generellt eftersom de förlorar blod under menstruationen.
– Många unga kvinnor idag är dessutom väldigt hälsomedvetna. Utmaningen med exempelvis en vegansk diet är om man inte sköter den tillräckligt bra. Animalisk kost är järnrik och avstår man det måste man kompensera järnintaget med järnrik vegansk kost. I kombination med mensen kan dålig kost göra att kvinnor får järnbrist, som i sin tur leder till blodbrist. Det är förödande för unga kvinnor som ska orka med att prestera fullt ut i både skola och inom idrott, säger Helena Kopp Kallner.
Trött och svimfärdig
Vid minsta misstanke om järnbrist ska du söka hjälp hos sjukvården. Vissa symptom är mer di!usa, vilket gör att man inte går till doktorn, menar Helena Kopp Kallner.
– Det är lurigt för symptomen kan komma under en lång period. Man ska till exempel aldrig ha klumpar i mensblod eller blod i avföring. Är det för sent i förloppet och du svimmar ofta, så kan det gå så långt som att
blodtransfusion behövs för att akut hämta upp blodvärdet.
Individuell behandling
Det är viktigt att inte bara testa hemoglobin eller blodvärdet vid misstanke om järnbrist. Läkaren bör även kolla TBIC (total järnbindningsförmåga) och Ferritinvärden, så man har tillräckligt med järn i kroppen för att kunna vara säker på att blodvärdet är tillräckligt för just den personen. – Mätskalorna för blodbrist är ibland inte helt tillförlitliga. Idag har vi mer och mer individuella reaktioner på hur mycket blod man ska ha i kroppen för att må bra. Det som är blodbrist för en person men behöver inte vara det för någon annan och därför är det också viktigt att få hjälp av din läkare för att hitta rätt behandling. Den individuella behandlingen måste utgå från orsaken till järnbristen, hur stort behovet är och vilka biverkningar man upplever, säger Helena Kopp Kallner.
SYMPTOM PÅ JÄRNBRIST
Yrsel när du ställer dig upp
Svaghetskänsla
Krypningar i benen Onaturlig trötthet Du kan känna dig svimfärdig
Maltofer (järn(III)hydroxidpolymaltoskomplex). 100 mg tuggtabletter, 2,5 mg/droppe, orala droppar, lösning. Maltofer används för att behandla och förebygga järnbrist. Maltofer tuggtabletter är endast avsedd för vuxna och ungdomar över 12 år. Varningar och försiktighet: Ta inte Maltofer om du: är allergisk mot polymaltoskomplex av järn(III)hydroxid eller något annat innehållsämne; har ett järnöverskott; har ett minskat antal röda blodkroppar (anemi), som ej orsakats av järnbrist; har störningar i järnanvändningen. Innan du använder Maltofer bör du rådfråga läkare för att undersöka om du har järnbrist. I så fall ska den underliggande orsaken till järnbristen utredas. Informera din läkare om du har en infektion eller tumör. Båda kan leda till minskat antal röda blodkroppar. Mörk missfärgning av avföringen kan uppstå under behandling med Maltofer. Detta är inte farligt. Kan orsaka diarré, illamående, buksmärtor, förstoppning. Tala om för läkare eller apotekspersonal om du tar, nyligen har tagit eller kan tänkas ta andra läkemedel. Graviditet, amning och fertilitet: Om du är gravid eller ammar, tror att du kan vara gravid eller planerar att skafa barn, rådfråga läkare eller apotekspersonal innan du använder detta läkemedel. Läs noga igenom bipacksedeln innan du börjar använda Maltofer. Den innehåller information som är viktig för dig.
KRÖNIKA
Livet är fullt av förväntningar och drömmar. För många är drömmen att bli förälder en stark och innerlig längtan. Men vad händer när den där drömmen inte infrias? När månaderna går och graviditetstestet fortsätter att visa negativt?
Text Riksförbundet Ofrivillig Barnlöshet
Ofrivillig barnlöshet är ett ämne som fortfarande är omgärdat av tystnad och skam. Det är en sjukdom som drabbar uppskattningsvis 10–15 % av alla par i Sverige, och som kan ha förödande konsekvenser för den psykiska hälsan.

och just nu i undersökningen om PGT-A.
Vi informerar och är länken mellan journalister och personer som vill dela sina historier.
Är du intresserad av att veta mer?
Besök vår hemsida barnloshetsverige.se eller följ oss på sociala medier.
Riksförbundet Ofrivillig Barnlöshet är en ideell organisation som finns för att stödja och informera alla som lever med ofrivillig barnlöshet. Sedan starten 1985 har vi även varit med och påverkat lagar och regler som rör ofrivillig barnlöshet. Vi har bland annat varit delaktiga i arbetet inför lagändringen 2016, då självstående kvinnor fick rätt till spermadonation.
Vi är aktiva i diskussionerna kring surrogatmödraskap, dubbeldonation

Vi arbetar också aktivt för att öka medvetenheten om ofrivillig barnlöshet i samhället. Tillsammans med de andra nordiska patientföreningarna kämpar vi för att fertilitetsmedvetenhet ska bli en del av undervisningen i skolan. Unga människor behöver veta hur de kan ta hand om sin fertilitet, så att de kan fatta informerade beslut om sin framtid. Alarmerande uppgifter visar att endast 12 procent av ungdomarna vet att fertiliteten minskar med åldern.*
Ofrivillig barnlöshet är inte bara en medicinsk fråga, det är också en existentiell. Det handlar om att konfronteras med sin egen kropp, sina
drömmar och sin identitet. Det är en kamp som är både fysiskt och psykiskt utmattande.
Men Riksförbundet Ofrivillig
Barnlöshet hoppas att vi tillsammans kan bryta tystnaden och skapa ett samhälle där ofrivillig barnlöshet inte längre är ett tabu.
Vår vision är tydlig: Vi vill se ett samhälle där ofrivillig barnlöshet inte längre är ett tabu, och där alla som vill ha barn får den hjälp de behöver. Vi strävar efter att öka kunskapen om ofrivillig barnlöshet, att ge stöd och information till drabbade, och att påverka politiken så att den bättre möter behoven hos de som kämpar för att få barn.
Hjälp oss sprida information om ofrivillig barnlöshet! Tillsammans kan vi göra skillnad!
* Preliminära rapporter från Fertility Europes FActs.




Var fjärde svensk lider av torra ögon utan att veta om det.1 Inte så konstigt då symtomen kan vara allt från suddig syn till trötta och irriterade ögon.














